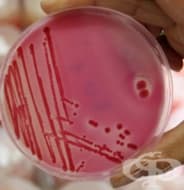
���������� �� ���������

Медицински изследвания
АКЦЕНТИ ОТ РУБРИКА ДИАГНОСТИЧНИ ПУНКЦИИ И БИОПСИЯ
ВсичкиАКТУАЛНО ОТ РУБРИКА ДИАГНОСТИЧНИ ПУНКЦИИ И БИОПСИЯ
АКЦЕНТИ ОТ РУБРИКА ИНСТРУМЕНТАЛНИ ИЗСЛЕДВАНИЯ
ВсичкиАКТУАЛНО ОТ РУБРИКА ИНСТРУМЕНТАЛНИ ИЗСЛЕДВАНИЯ
АКЦЕНТИ ОТ РУБРИКА КЛИНИЧНО ИЗСЛЕДВАНЕ
ВсичкиАКТУАЛНО ОТ РУБРИКА КЛИНИЧНО ИЗСЛЕДВАНЕ
АКЦЕНТИ ОТ РУБРИКА ЛАБОРАТОРНИ ИЗСЛЕДВАНИЯ
ВсичкиАКТУАЛНО ОТ РУБРИКА ЛАБОРАТОРНИ ИЗСЛЕДВАНИЯ
АКЦЕНТИ ОТ РУБРИКА ПАТОМОРФОЛОГИЯ - ЦИТОЛОГИЧНО, ХИСТОЛОГИЧНО, ИМУНОХИСТОХИМИЧНО, ИМУНОФЛУОРЕСЦЕНТНО И ЕЛЕКТРОННО-МИКРОСКОПСКО ИЗСЛЕДВАНЕ
ВсичкиВСИЧКИ СТАТИИ

Артрография на рамо
Артрографията на рамо представлява изследване, при което се инжектира рентгеноконтрастна материя в с...

Изследване за дизентерия
Дизентерията е остро инфекциозно заболяване. Причинява се от бактерии от род Shigella, поради което ...

Креатинин в кръвта
Нивото на креатинин в кръвта е важен показател за състоянието на бъбреците и тяхната функция, защото...

Спермограма
Анализът на семенната течност е един от първите и най-важни тестове, който се прилага, за да се уста...

Тест на Шилинг
Тестът на Шилинг представлява изследване за абсорбция на витамин В12. Чрез него се установява дали о...
Изследване за салмонела
Бактериите от род салмонела причиняват три групи заболявания при човека:Тифно-паратифни (коремен тиф...
Медицински изследвания накратко
Медицинските изследвания са вид медицинска манипулация, която има за цел да открие, диагностицира или оцени различни заболявания или склонност към тях, както и ефекта от проведената терапия. Тези изследвания могат да бъдат диагностични, скринингови или с оценителен характер.
Диагностичните изследвания се използват за потвърждаване на диагноза или за откриване на причината за дадено заболяване въз основа на данните от симптомите. Такива диагностични изследвания са например изследването на кръвната захар при пациенти със съмнение за захарен диабет, изследване на пълна кръвна картина при пациенти с висока температура и съмнение за бактериална инфекция, назначаване на електрокардиограма при болка в гърдите за откриване на сърдечни нарушения.
Скрининговите изследвания се провеждат за откриване на заболявания при хора с повишен индивидуален риск, фамилна предиспозиция или повишен професионален риск. Скрининговите изследвания се използват за мониториране на повишена заболяемост, за установяване на епидемиологични данни, с цел превенция, или за статистически цели.
Пример за такива изследвания са изследване на нивата на ТСХ в кръвта при новородени като част от скрининг за вроден хипотиреоидизъм, скрининг за рак на белия дроб при непушачи в рискова професионална среда, цитонамазка за ранна диагностика на рак на маточната шийка.
Някои медицински изследвания се провеждат за оценка на прогреса на заболяването или за оценка на ефекта от проведената терапия. Те могат да бъдат използвани и за оценка на прогнозата на дадено заболяване.
Пример за такива изследвания са кръвно-газовият анализ след диагностициран пневмоторакс с рентгеново изследване или провеждане на биопсия за определяне на степен на злокачественост (малигненост).
Някои медицински изследвания са свързани с повишен здравословен риск и дори за провеждането им е необходима пълна анестезия, както е например медиастиноскопията. Други изследвания като кръвните или цитонамазката имат минимален или дори никакъв риск. Медицинските изследвания може да водят до индиректен риск като например стрес от изследването или получаване на фалшиво положителни резултати от тестовете.




























